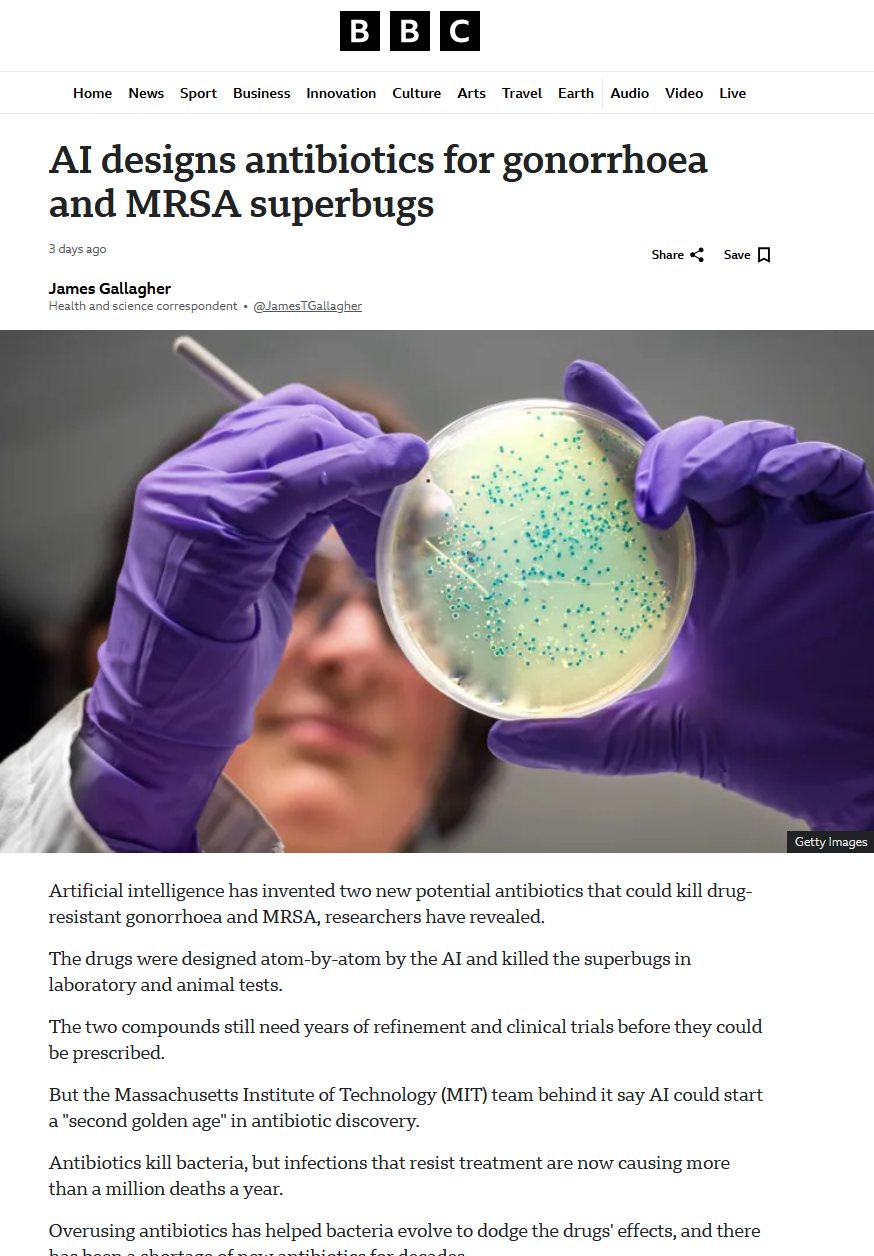

옛날에 XP 쓰던 시절 트래픽 상태 보기 편하게 디스플레이 하는 프로그램을 썼는데 그 뒤로 마땅한 걸 못찾음…
옛날에 XP 쓰던 시절 트래픽 상태 보기 편하게 디스플레이 하는 프로그램을 썼는데 그 뒤로 마땅한 걸 못찾음. 오늘 갑자기 생각나서 Claude 에게 psutil로 디스플레이 하는 앱을 만들어달라고 부탁. 최근 10분간 최대 트래픽에 맞춰 scale 조절. 몇차례 수정 뒤 완성. 이 정도면 좀 손이 많이 가는 자비스 아니겠나.


옛날에 XP 쓰던 시절 트래픽 상태 보기 편하게 디스플레이 하는 프로그램을 썼는데 그 뒤로 마땅한 걸 못찾음. 오늘 갑자기 생각나서 Claude 에게 psutil로 디스플레이 하는 앱을 만들어달라고 부탁. 최근 10분간 최대 트래픽에 맞춰 scale 조절. 몇차례 수정 뒤 완성. 이 정도면 좀 손이 많이 가는 자비스 아니겠나.


ET 2 주인공 배역 마저 페드로 파스칼이 가져갔다는 소문이


빌 게이츠 기고문에 동감한다. 미국은 WHO에서 탈퇴하고 기금을 내년부터 더 이상 내지 않는다고 선언했다. 세계 보건 거버넌스에서 미국의 공백이 커지면, 한국이 추가로 맡을 수 있는 자리가 분명히 있다. Gavi, 글로벌펀드, WHO 세 축은 단순한 원조 기구가 아니라 전 세계 보건의 흐름을 결정하는 무대이다. 여기서 한국이 자금을 더 내고 목소리를 내면 어떤 기회가 생기는지 짚어볼 필요가 있다. 무엇보다 이런 역할 확대는 한국이 도덕적 지도력을 갖는 계기가 된다. 단순히 돈을 내는 후원자가 아니라, 세계 보건의 형평성과 접근성을 실질적으로 지켜내는 리더로 자리 잡을 수 있다. 결국 세 기구에 대한 한국의 추가 기여는 ‘책임 있는 중견국’ 이미지를 넘어, 한국을 대안적 보건 리더십의 상징으로 만드는 길이다. 그리고 Gavi(세계백신면역연합)에서는 백신 조달과 배분 정책을 좌우할 수 있다. SK바이오사이언스, 삼성바이오로직스, 셀트리온, 한미 같은 한국 기업들은 이미 글로벌 백신 시장에 뛰어들었고, 한국 정부가 Gavi를 더 강하게 지원하면 한국산 백신이 저개발국가로 들어가는 통로가 넓어진다. 단순한 수출이 아니라 ‘공공재 공급자’라는 국가 이미지가 덧붙는 것이다. 글로벌펀드는 에이즈, 결핵, 말라리아 같은 전염병 대응 자금을 모으는 핵심 기구이다. 여기에 한국이 대규모 자금을 내면 아프리카와 동남아 보건 현장에서 한국의 존재감이 커진다. 한국산 제네릭·바이오시밀러 의약품이 공식 조달 루트로 들어가면 한국 제약산업이 글로벌 신뢰도를 쌓는 계기가 된다. 중국이 오랫동안 아프리카에서 영향력을 확대해온 것처럼, 한국에게 이건 아프리카를 중심으로 글로벌 보건 외교력을 넓힐 좋은 기회이다. 중국과 일본, 유럽은 이미 많이 내고 있는 상황이라 미국의 빈자리를 채워 더 얻을 수 있는 영향력에 제한이 있다. 지금 이건 한국을 위해 만들어진 기회다. WHO는 국제 규범과 기준을 세우는 자리이다. 동시에 지금 미국은 전 세계에 자국민과 같은 수준의 높은 약값을 강요하려 하고 있다. 최소 절충으로 우리가 지금 부담하는 금액과 미국 가격 중간 쯤이 될 가능성도 있다. 미국 제약회사가 만들어낸 고가 약값 구조를 세계 시장에 그대로 적용하려는 흐름은 많은 나라들에게 큰 부담이 된다. 그러나 이 공백은 한국에게 기회이다. 한국은 비교적 합리적 가격에 고품질 의약품과 백신을 공급할 수 있고, WHO와 Gavi, 글로벌펀드와의 협력을 강화한다면 ‘미국식 고가 모델’에 대한 실질적 대안으로 자리매김할 수 있다. 다시 말해 한국이 내는 추가 기여금은 단순한 재정지원이 아니라, 세계 제약질서의 균형을 새로 짜는 카드가 된다. 미국이 빠져나간 뒤 한국이 자금을 채워넣으면 의제 설정에서 발언권이 더해진다. 감염병 대응, 보건 디지털화, 가격 접근성 같은 주제에서 한국이 주도권을 쥘 수 있다. 이는 단순히 돈을 내는 것이 아니라 세계 보건의 방향을 설계하는 위치에 서는 것이다. 또한 앞으로 주기적으로 새로운 전염병이 출현할 가능성이 높아지고 있어, WHO와 한국의 역할은 더욱 커질 수밖에 없다. 한국이 이 영역에서 선제적으로 투자하고 리더십을 발휘한다면, 세계적 위기 때마다 신뢰받는 중심축으로 자리잡게 된다. 코로나19 대응에서도 한국은 비교적 성공적인 방역 모델을 보여주며 국제적 신뢰를 얻었다. 이 경험은 한국이 미래 전염병 예방 정책을 설계하고 주도하는 데 강력한 자산이 된다. 이 과정에서 필요한 예산도 결코 부담스러운 규모가 아니다. WHO, Gavi, 글로벌펀드를 합쳐 연간 9억~15억 달러 정도의 기여로도 한국은 상위 기여국 반열에 오를 수 있다. 이는 한국 국력에서 보면 아주 작은 금액이지만, 실제로는 인류에게 가장 적은 노력으로 가장 크게 도움을 줄 수 있는 길이다. 또한 한국 제약·바이오 기업은 이 기여를 통해 세계 조달망과 직접 연결될 수 있다. 삼성바이오로직스, 셀트리온, SK바이오사이언스 같은 기업들이 백신, 바이오시밀러, CDMO 영역에서 시장 점유율을 넓히고 글로벌 신뢰를 확보하는 계기가 된다. 산업적 이익과 국가적 명분이 동시에 확보되는 것이다. 좋은 일을 하면서도, 한국이 투입한 금액 이상을 한국 기업들이 다시 벌어들일 수 있는 가능성이 크다.







꽤 쓸만하게 나온다 #midjourney



조만간 수요가 확 생길 것 같은데. 중국 한푸도 한 번 온라인에서 쉽쓸고 지나갔지만 한복은 서양분들도 직접 사/만들어 입어보고 싶어할 듯. 한국 문화나 중국 문화나 서양 사람들 입장에서 봤을 때 비슷할 수 있는데 하나는 즐길 수 있고 하나는 즐기기 힘든 이유는 국가주의임. 남의 나라 국가주의는 누구에게나 역겨운 법. 한국은 국뽕 드라마/영화에서 비교적 좀 빨리 벗어난 편. 중국은 아직 내수 시장이 국뽕 위주고. #midjourney









항생제가 더 이상 듣지 않는 특정 균에 대해 생성형 AI로 3600만개의 항생제 조합을 만들고 테스트해서 효과 있는 조합을 이미 찾았다. 생쥐를 감염시키는 균을 가지고 실험했을 때는 효과가 있었고 인간 임상 시작은 아직 2년 정도 앞두고 있다. AI가 인류에게 닥친 문제들 대부분을 해결할 것으로 생각한다.

라디오헤드 Let Down 코러스의 가성이 터져 나오면, 설명이 필요 없다. 목소리 톤이 먼저 감정을 끌어올린다. 이성과정 이전에 이미 몸이 흔들린다. 연구들은 이 현상을 뒷받침한다. 한 실험에서는 음의 높낮이를 바꾸자 감정 상태뿐 아니라 신체 움직임과 근육 감각, 자기 몸에 대한 느낌까지 달라졌다. 또 다른 연구에서는 목소리를 더 행복하거나 슬프게 들리도록 청각 피드백을 조작했더니, 실제 감정이 그 방향으로 변했다. 음악학에서는 이를 “frisson(전율)”이라 부른다. 예측 불가능한 고음이나 갑작스러운 화성 변화 같은 자극이 몸 전체를 전율하게 만든다. 유재석의 웃음소리도 같은 원리다. 상황이 그리 웃기지 않아도 그의 웃음을 들으면 먼저 따라 웃게 된다. 영국 UCL 소피 스콧 교수 연구팀은 웃음소리를 들을 때 얼굴 근육을 움직이는 뇌 영역이 활성화된다고 밝혔다. 들리는 순간 뇌가 웃을 준비를 하는 것이다. 메릴랜드대 로버트 프로바인 교수는 “혼자 있을 때보다 타인과 함께 있을 때 웃을 확률이 30배 높다”며 웃음이 뇌 대 뇌로 전염된다고 설명했다. 숭실대 배명진 교수팀은 개그맨들의 웃음을 정감성, 파급성, 다양성, 울림성, 목젖울림, 청음도 여섯 항목으로 평가했다. 유재석은 ‘목젖울림’과 ‘파급성’에서 최고 점수를 받았다. 배 교수는 “숨 넘어가는 깔깔 웃음이 웃음 바이러스를 퍼뜨린다”고 분석했다. 유재석도 이걸 남용하지는 않는다. 분위기를 띄워야 하는 상황에서만 사용한다. 목소리 톤은 단순한 소리가 아니다. 감정을 건드리는 트리거다. 듣는 순간 이미 반응이 시작된다. 의미를 해석하기도 전에 마음이 흔들린다. 방송인들이 방송 종류에 따라 목소리 높낮이를 미리 조절하는 이유도 같다.



노스캐롤라이나는 작은 땅덩이에 비해, 혹은 겨우 300년 정도 밖에 안된 그 지역 영어 사용 역사에 비해 방언의 다양성이 놀라울 정도로 크다. 서쪽으로는 애팔래치아 산맥이 자리 잡아 스코틀랜드와 아일랜드 이민자들의 영어가 뿌리내렸다. 여기서는 고유의 억양과 단어들이 살아남아 “Appalachian English”라 불리는데, 리듬감 있는 억양과 보수적인 어휘 보존이 특징이다. 오랜 고립 덕분에 마치 언어의 박물관 같은 역할을 하고 있다. 반대로 동쪽 아우터뱅스 지역은 바다로 둘러싸인 섬과 해안 공동체에서 독특한 “Hoi Toider” 억양이 발달했다. 낚시와 뱃일을 생업으로 삼던 이들의 말투는 오랜 기간 내륙과 단절되며 영국 서남부 억양이 살아 있어, 오늘날에도 외부인이 들으면 마치 다른 나라 말처럼 들릴 정도다. 중부의 ‘리서치 트라이앵글(랄리, 더럼, 채플힐)’은 학계와 첨단 산업 종사자들이 몰리면서 전형적인 남부 억양이 약화되고 있다. 전국 각지에서 모인 연구자와 엔지니어들이 표준 영어에 가까운 발음을 쓰면서, 이 지역은 노스캐롤라이나 안에서도 언어적으로 가장 ‘중립적’인 곳으로 변해가고 있다. 역사적으로 보면, 산악지역은 스코틀랜드-아일랜드계, 해안은 영국 해양도시 출신 이민자, 내륙은 플랜테이션과 도시화의 영향을 받아 다른 색을 띠었다. 여기에 최근 수십 년간의 인구 유입이 더해지며 방언의 차이는 더욱 뚜렷하거나, 반대로 희석되기도 했다. 특히 노스캐롤라이나 개척자들이 서쪽으로 이동해 테네시 개척에 참여하면서 그들의 방언이 그대로 이어졌다. 애팔래치아 산맥을 따라 이어진 정착촌들은 서로 밀접하게 연결되어 있었고, 같은 스코틀랜드-아일랜드계 혈통을 공유한 정착민들이 유사한 억양과 표현을 퍼뜨렸다. 그 결과 테네시, 켄터키, 웨스트버지니아 등지의 산악 방언들은 노스캐롤라이나 서부 방언과 매우 비슷한 특징을 보인다. 예를 들어 단어 끝의 -ing를 -in’으로 발음하거나, ‘y’all’을 기본 복수 인칭 대명사로 쓰는 습관은 이 지역 전반에 퍼져 있다. 더 나아가 이 같은 개척의 흐름은 오자크 산맥 지역까지 이어졌다. 오늘날 아칸소와 미주리 오자크 지역은 문화적으로도 애팔래치아와 닮은 점이 많다. 실제로 초기 개척자 상당수가 노스캐롤라이나·버지니아·테네시 산악지대 출신이었기 때문에, 언어적으로도 공통성이 뚜렷하다. 그래서 오자크 영어 역시 ‘산악 방언(mountain dialect)’으로 묶이며, 애팔래치아 영어와 매우 비슷한 발음, 어휘, 문법적 특징을 공유한다. 오자크 지방의 전통 음악이나 민속도 애팔래치아와 크게 닮아 있는 것은 이런 개척사적 연속성 때문이다. 결국 노스캐롤라이나의 언어적 풍경은 한 주의 경계를 넘어서 남부 내륙 전역에 영향을 미쳤다. 테네시와 켄터키는 물론, 멀리 오자크 산맥까지 같은 뿌리를 가진 말씨와 생활양식이 확산되었고, 이는 오늘날에도 여전히 들을 수 있는 독특한 산악 영어의 전통으로 이어지고 있다. 또 동시에 노스캐롤라이나주 내부 안에서도 확연히 다른 다양한 방언을 오늘날까지 유지하고 있다. 방언의 백화점이라 할 만하다.




잘 모르는 분인데 시진핑 실각설도 그렇고 좀 작은 부분에 크게 꽂히는 성향이 있으신 듯. 미국도 러시아 도움이 아쉬울 수 있는 상황이었다는 정황 하나 가지고 "이건 어떻게 설명할거냐! 따라서 니들 다 틀렸다!" 하고 너무 큰 해석을…
더 넓게 더 많이 봐야 함.

계단 올라갈 때 무릎 아픈 분들은 고통을 확 줄이는 방법이 있다. 핵심은 무릎 근육보다 엉덩이 근육을 활용하는 거다. 요령은 윗계단에 올린 다리를 앞으로 굽히지 않고 최대한 수직으로 바로 세운 상태에서 몸을 들어 올리는데 엉덩이 근육을 써서 올린다. 몸이 약간 앞으로 기울며 체중이 앞으로 쏠린 상태에서 올라간다. 이렇게 하면 올라가며 무릎에 힘줘 펴야하는 각도를 줄여서 무릎에 가는 하중을 확 줄여준다. 이 영상 참고. https://www.youtube.com/shorts/vY7ONoXlJ20
